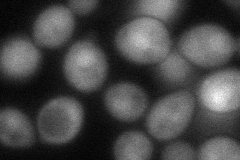
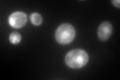

View description
Thioredoxin peroxidase, acts as both a ribosome-associated and free cytoplasmic antioxidant; self-associates to form a high-molecular weight chaperone complex under oxidative stress; deletion results in mutator phenotype
Localization:
Intensity:
Fold change:
Significance:
-
C’ GFP library in SD

cytosol982.33 -
N' NOP1pr-GFP in SD

cytosol401.437 -
N' TEF2pr-mCherry in SD

cytosol456.901 -
N' NATIVEpr-GFP in SD

cytosol663.576 -
N' TEF2pr-VC and Cyto-VN in SD
cytosol64.4087 -
C’ GFP library in SD+DTT

cytosol1698.571.72Yes -
C’ GFP library in SD+H2O2

punctateN/AN/ANo -
C’ GFP library in Starvation Media
nucleus1292.521.31No -
C’ GFP library on the background of Pup2-DaMP

punctate -
C’ GFP library on the background of CCT mutant

cytosol1292.531.31576Yes
